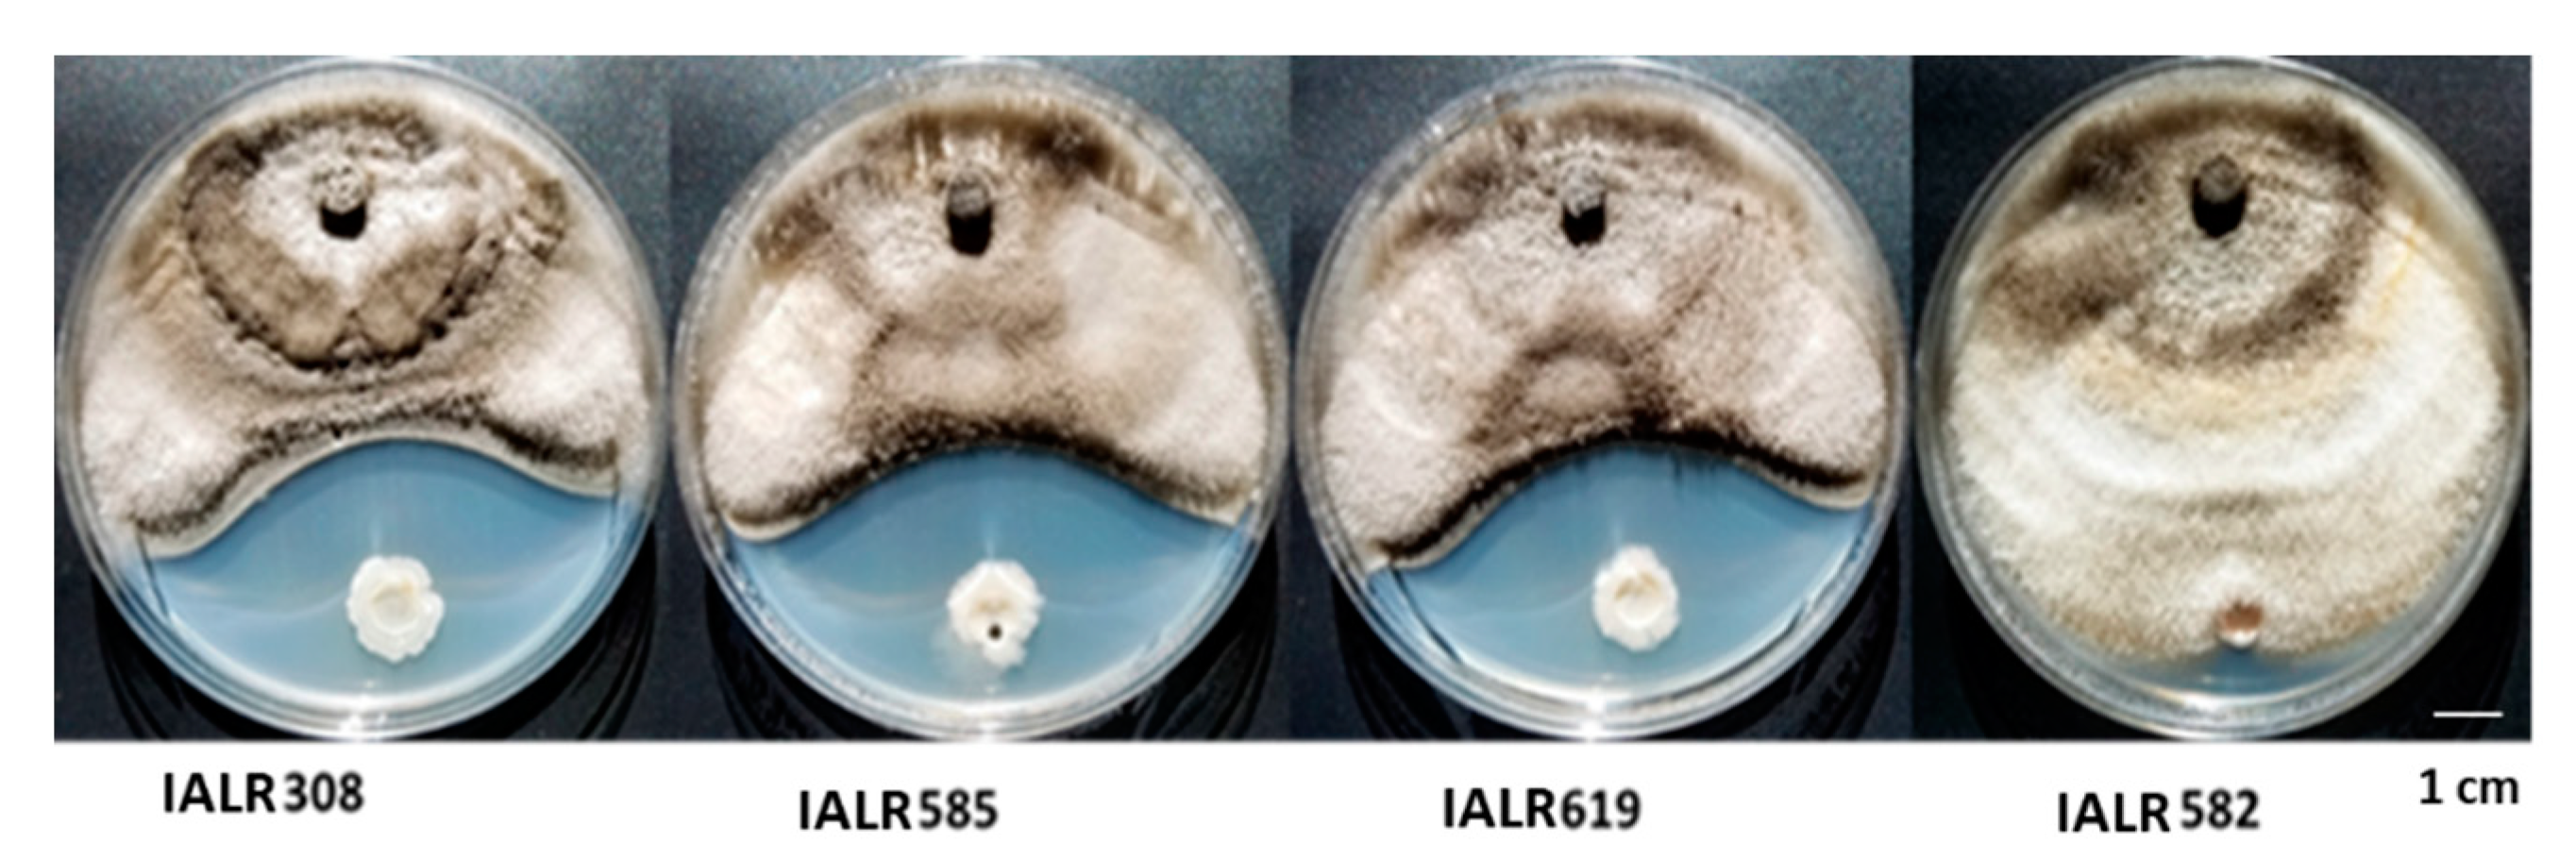
Horticulturae 07 00504 g001 550

A Potential Application of Endophytic Bacteria in Strawberry Production
Abstract
:1. Introduction
2. Materials and Methods
2.1. Plant Materials and Endophytic Bacteria
2.2. In Vitro Antifungal Screening
2.3. Plant Growth-Promoting Traits
2.3.1. Auxin Quantification
2.3.2. Phosphate Solubilizing Ability
2.3.3. Nitrogen Fixation and ACC Deaminase Activity Screening and Siderophore Production
2.4. Greenhouse Experiments
2.5. Fruit Yields in the Field Trials
2.6. Genomic Sequencing and Analysis and Phylogenic Tree Construction
2.7. Quantification of Antibiotic Compounds Produced by Bacterial Endophytes
2.8. Statistical Analysis
3. Results
3.1. Origination and Identification of Potential Endophytic Bacteria
3.2. Screening Endophytic Bacteria against Strawberry Pathogen Growth in Plate Assay
3.3. Plant Growth-Promoting Traits of Endophytic Bacteria
3.4. Disease Reduction in the Greenhouse Test
3.5. Growth Promotion in the Greenhouse Experiments
3.6. Field Trials in Different Locations
3.7. Genome Sequence Analysis of IALR619 Strain and Phylogenetic Tree
3.8. Antibiotic Compounds Produced by Endophytic Bacteria
4. Discussion
Author Contributions
Funding
Institutional Review Board Statement
Informed Consent Statement
Data Availability Statement
Acknowledgments
Conflicts of Interest
References
- Shahbandeh, M. Per Capita Consumption of Fresh Strawberries in the United States from 2000 to 2019. U.S. Fresh Strawberries Consumption per Capita 2018|Statista. 2021. Available online: https://www.statista.com/statistics/823192/us-per-capita-consumption-of-fresh-strawberries/ (accessed on 22 September 2021).
- Samtani, J.B.; Rom, C.R.; Friedrich, H.; Fennimore, S.A.; Finn, C.E.; Petran, A.; Wallace, R.W.; Pritts, M.P.; Fernandez, G.; Chase, C.A.; et al. The status and future of the strawberry industry in the United States. HortTechnology 2019, 29, 11–24. [Google Scholar] [CrossRef] [Green Version]
- Goodhue, R.E.; Fennimore, S.A.; Ajwa, H.A. The economic importance of methyl bromide: Does the California strawberry industry qualify for a critical use exemption from the methyl bromide ban? Appl. Econ. Perspect. Policy 2005, 27, 198–211. [Google Scholar] [CrossRef]
- Christman, J.; Samtani, J. A survey of strawberry production practices in Virginia. Va. Coop. Ext. Publ. 2019, SPES-150P, 1–6. [Google Scholar]
- Mei, C.; Flinn, B.S. The use of beneficial microbial endophytes for plant biomass and stress tolerance improvement. Recent Pat. Biotechnol. 2010, 4, 81–95. [Google Scholar] [CrossRef] [PubMed]
- Glick, B.R. Plant growth-promoting bacteria: Mechanisms and applications. Scientifica 2012, 2012, 963401. [Google Scholar] [CrossRef] [PubMed] [Green Version]
- Olanrewaju, O.S.; Glick, B.R.; Babalola, O.O. Mechanisms of action of plant growth promoting bacteria. World J. Microbiol. Biotechnol. 2017, 33, 197. [Google Scholar] [CrossRef] [Green Version]
- Afzal, M.; Khan, Q.M.; Sessitsch, A. Endophytic bacteria: Prospects and applications for the phytoremediation of organic pollutants. Chemosphere 2014, 117, 232–242. [Google Scholar] [CrossRef]
- Kandel, S.L.; Joubert, P.M.; Doty, S.L. Bacterial endophyte colonization and distribution within plants. Microorganisms 2017, 5, 77. [Google Scholar] [CrossRef] [Green Version]
- Compant, S.; Cambon, M.C.; Vacher, C.; Mitter, B.; Samad, A.; Sessitsch, A. The plant endosphere world–bacterial life within plants. Environ. Microbiol. 2021, 23, 1812–1829. [Google Scholar] [CrossRef]
- Kim, H.J.; Lee, S.H.; Kim, C.S.; Lim, E.K.; Choi, K.H.; Kong, H.G.; Kim, D.W.; Lee, S.W.; Moon, B.J. Biological control of strawberry gray mold caused by Botrytis cinerea using Bacillus licheniformis N1 formulation. J. Microbiol. Biotechnol. 2007, 17, 438–444. [Google Scholar]
- Tortora, M.L.; Díaz-Ricci, J.C.; Pedraza, R.O. Azospirillum brasilense siderophores with antifungal activity against Colletotrichum acutatum. Arch. Microbiol. 2011, 193, 275–286. [Google Scholar] [CrossRef] [PubMed]
- Cha, J.Y.; Han, S.; Hong, H.J.; Cho, H.; Kim, D.; Kwon, Y.; Kwon, S.K.; Crüsemann, M.; Lee, Y.B.; Kim, J.F.; et al. Microbial and biochemical basis of a Fusarium wilt-suppressive soil. ISME J. 2016, 10, 119–129. [Google Scholar] [CrossRef] [Green Version]
- Todeschini, V.; AitLahmidi, N.; Mazzucco, E.; Marsano, F.; Gosetti, F.; Robotti, E.; Bona, E.; Massa, N.; Bonneau, L.; Marengo, E.; et al. Impact of beneficial microorganisms on strawberry growth, fruit production, nutritional quality, and volatilome. Front. Plant Sci. 2018, 9, 1611. [Google Scholar] [CrossRef]
- de Andrade, F.M.; de Assis Pereira, T.; Souza, T.P.; Guimarães, P.H.; Martins, A.D.; Schwan, R.F.; Pasqual, M.; Dória, J. Beneficial effects of inoculation of growth-promoting bacteria in strawberry. Microbiol. Res. 2019, 223, 120–128. [Google Scholar] [CrossRef] [PubMed]
- Chen, X.H.; Vater, J.; Piel, J.; Franke, P.; Scholz, R.; Schneider, K.; Koumoutsi, A.; Hitzeroth, G.; Grammel, N.; Strittmatter, A.W.; et al. Structural and functional characterization of three polyketide synthase gene clusters in Bacillus amyloliquefaciens FZB 42. J. Bacteriol. 2006, 188, 4024–4036. [Google Scholar] [CrossRef] [PubMed] [Green Version]
- Mei, C.; Chretien, R.L.; Amaradasa, B.S.; He, Y.; Turner, A.; Lowman, S. Characterization of phosphate solubilizing bacterial endophytes and plant growth promotion in vitro and in greenhouse. Microorganisms 2021, 9, 1935. [Google Scholar] [CrossRef]
- Kim-Dura, S.; Lowman, S.; Zhang, S.; Mei, C. Growth promotion of switchgrass by bacterial endophyte Pantoea agglomerans strain PaKM isolated from seeds. J. Pathol. Microbiol. 2016, 1, 1–9. [Google Scholar]
- Patten, C.L.; Glick, B.R. Role of Pseudomonas putida indoleacetic acid in development of the host plant root system. Appl. Environ. Microbiol. 2002, 68, 3795–3801. [Google Scholar] [CrossRef] [PubMed] [Green Version]
- Murphy, J.A.; Riley, J.P. A modified single solution method for the determination of phosphate in natural waters. Anal. Chim. Acta 1962, 27, 31–36. [Google Scholar] [CrossRef]
- Bolger, A.M.; Lohse, M.; Usadel, B. Trimmomatic: A flexible trimmer for Illumina sequence data. Bioinformatics 2014, 30, 2114–2120. [Google Scholar] [CrossRef] [Green Version]
- Zerbino, D.R.; Birney, E. Velvet: Algorithms for de novo short read assembly using de Bruijn graphs. Genome Res. 2008, 18, 821–829. [Google Scholar] [CrossRef] [PubMed] [Green Version]
- Hyatt, D.; Chen, G.; Locascio, P.; Land, M.; Larimer, F.; Hauser, L. BMC bioinformatics [electronic resource]. BMC Bioinform. 2010, 11, 119. [Google Scholar]
- Chan, P.P.; Lowe, T.M. tRNAscan-SE: Searching for tRNA genes in genomic sequences. In Gene Prediction; Humana: New York, NY, USA, 2019; pp. 1–14. [Google Scholar]
- Darling, A.E.; Mau, B.; Perna, N.T. progressiveMauve: Multiple genome alignment with gene gain, loss and rearrangement. PLoS ONE 2010, 5, e11147. [Google Scholar] [CrossRef] [PubMed] [Green Version]
- Aziz, R.K.; Bartels, D.; Best, A.A.; DeJongh, M.; Disz, T.; Edwards, R.A.; Formsma, K.; Gerdes, S.; Glass, E.M.; Kubal, M.; et al. The RAST Server: Rapid annotations using subsystems technology. BMC Genom. 2008, 9, 75. [Google Scholar] [CrossRef] [PubMed] [Green Version]
- Emms, D.M.; Kelly, S. OrthoFinder: Solving fundamental biases in whole genome comparisons dramatically improves orthogroup inference accuracy. Genome Biol. 2015, 16, 157. [Google Scholar] [CrossRef] [PubMed] [Green Version]
- Emms, D.M.; Kelly, S. STAG: Species tree inference from all genes. BioRxiv 2018, 267914. [Google Scholar] [CrossRef]
- Emms, D.M.; Kelly, S. STRIDE: Species tree root inference from gene duplication events. Mol. Biol. Evol. 2017, 34, 3267–3278. [Google Scholar] [CrossRef] [PubMed]
- Kim, S.Y.; Lee, S.Y.; Weon, H.Y.; Sang, M.K.; Song, J. Complete genome sequence of Bacillus velezensis M75, a biocontrol agent against fungal plant pathogens, isolated from cotton waste. J. Biotechnol. 2017, 241, 112–115. [Google Scholar] [CrossRef]
- Pastrana, A.M.; Basallote-Ureba, M.J.; Aguado, A.; Akdi, K.; Capote, N. Biological control of strawberry soilborne pathogens Macrophomina phaseolina and Fusarium solani, using Trichoderma asperellum and Bacillus spp. Phytopathol. Mediterr. 2016, 1, 109–120. [Google Scholar]
- Khalil, S.; Svensson, B. Biological control of root pathogens in strawberry cultivation in tunnel. In VIII International Strawberry Symposium; ISHS Acta Horticulturae: Québec City, Canada, 2016; pp. 811–816. [Google Scholar]
- Marian, M.; Ohno, T.; Suzuki, H.; Kitamura, H.; Kuroda, K.; Shimizu, M. A novel strain of endophytic Streptomyces for the biocontrol of strawberry anthracnose caused by Glomerella cingulata. Microbiol. Res. 2020, 234, 126428. [Google Scholar] [CrossRef]
- Bona, E.; Lingua, G.; Manassero, P.; Cantamessa, S.; Marsano, F.; Todeschini, V.; Copetta, A.; D’Agostino, G.; Massa, N.; Avidano, L.; et al. AM fungi and PGP pseudomonads increase flowering, fruit production, and vitamin content in strawberry grown at low nitrogen and phosphorus levels. Mycorrhiza 2015, 25, 181–193. [Google Scholar] [CrossRef] [PubMed]
- Nam, M.H.; Park, M.S.; Kim, H.G.; Yoo, S.J. Biological control of strawberry Fusarium wilt caused by Fusarium oxysporum f. sp. fragariae using Bacillus velezensis BS87 and RK1 formulation. J. Microbiol. Biotechnol. 2009, 19, 520–524. [Google Scholar] [CrossRef] [PubMed] [Green Version]
- Rabbee, M.F.; Ali, M.D.; Choi, J.; Hwang, B.S.; Jeong, S.C.; Baek, K.H. Bacillus velezensis: A valuable member of bioactive molecules within plant microbiomes. Molecules 2019, 24, 1046. [Google Scholar] [CrossRef] [Green Version]
- Aleti, G.; Sessitsch, A.; Brader, G. Genome mining: Prediction of lipopeptides and polyketides from Bacillus and related Firmicutes. Comput. Struct. Biotechnol. J. 2015, 13, 192–203. [Google Scholar] [CrossRef] [PubMed]
- Cawoy, H.; Bettiol, W.; Fickers, P.; Ongena, M. Bacillus-based biological control of plant diseases. In Pesticides in the Modern World-Pesticides Use and Management; Stoytcheva, M., Ed.; IntechOpen: London, UK, 2011; pp. 273–302. [Google Scholar]

| Strains | Species | Accession Number | Tissues | Plants |
|---|---|---|---|---|
| IALR308 | Bacillusvelezensis | OK584762 | Shoot | Vitis spp. |
| IALR585 | Bacillus velezensis | OK584763 | Shoot | Trifolium repens |
| IALR619 | Bacillus velezensis | OK584764 | Leaf | Salix atrocinerea |
| Traits | Bacillus velezensis IALR308 | Bacillus velezensis IALR585 | Bacillus velezensis IALR619 |
|---|---|---|---|
| Auxin (µg/mL) | 9.6 ± 0.8 | 6.7 ± 0.6 | 7.5 ± 0.1 |
| P content (µg/mL) | 20.4 ± 3.3 | 16.0 ± 0.1 | 15.3 ± 2.4 |
| Treatments | Marketable Yield | Non-Marketable Yield | Total Yield |
|---|---|---|---|
| IALR619 (Fall + Spring) | 519.6 b * | 144.2 | 663.8 |
| IALR619 (Fall) | 463.2 ab | 145.5 | 608.7 |
| Non-treated control | 429.8 a | 155.5 | 585.2 |
| p-value | 0.0425 | 0.1425 | 0.0655 |
| Features | Value |
|---|---|
| Gene total length (bp) | 3,871,487 |
| Maximum contig length (bp) | 1,068,237 |
| N50 (bp) | 1,020,364 |
| Depth of genome coverage | 67 |
| Gene average length (bp) | 101,881 |
| Chromosome number | 1 |
| GC content in gene region (%) | 46.6 |
| Protein-coding genes (CDSs) | 3783 |
| rRNA genes | 4 |
| tRNA genes | 66 |
| Antibiotics (µg/mL) | Bacillus velezensis IALR308 | Bacillus velezensis IALR585 | Bacillus velezensis IALR619 |
|---|---|---|---|
| Surfactin | ND | 80.2 ± 7.9 | 39.5 ± 2.2 |
| Iturin | ND | 206.8 ± 8.7 | 33.2 ± 0.7 |
Publisher’s Note: MDPI stays neutral with regard to jurisdictional claims in published maps and institutional affiliations. |
© 2021 by the authors. Licensee MDPI, Basel, Switzerland. This article is an open access article distributed under the terms and conditions of the Creative Commons Attribution (CC BY) license (https://creativecommons.org/licenses/by/4.0/).
Share and Cite
Mei, C.; Amaradasa, B.S.; Chretien, R.L.; Liu, D.; Snead, G.; Samtani, J.B.; Lowman, S. A Potential Application of Endophytic Bacteria in Strawberry Production. Horticulturae 2021, 7, 504. https://doi.org/10.3390/horticulturae7110504
Mei C, Amaradasa BS, Chretien RL, Liu D, Snead G, Samtani JB, Lowman S. A Potential Application of Endophytic Bacteria in Strawberry Production. Horticulturae. 2021; 7(11):504. https://doi.org/10.3390/horticulturae7110504
Chicago/Turabian StyleMei, Chuansheng, B. Sajeewa Amaradasa, Robert L. Chretien, Danyang Liu, George Snead, Jayesh B. Samtani, and Scott Lowman. 2021. "A Potential Application of Endophytic Bacteria in Strawberry Production" Horticulturae 7, no. 11: 504. https://doi.org/10.3390/horticulturae7110504
APA StyleMei, C., Amaradasa, B. S., Chretien, R. L., Liu, D., Snead, G., Samtani, J. B., & Lowman, S. (2021). A Potential Application of Endophytic Bacteria in Strawberry Production. Horticulturae, 7(11), 504. https://doi.org/10.3390/horticulturae7110504







